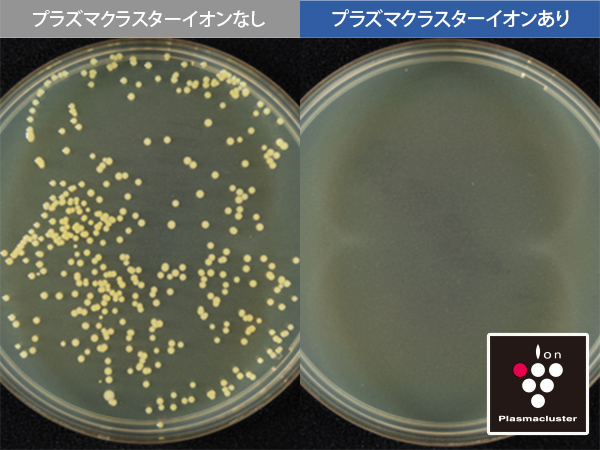

特長

メガフリーザー170L※
たっぷり⼊るから、まとめ買いも快適。充実の鮮度⻑持ち機能で、⾁・⿂・野菜も⼿作り総菜も、フレッシュな味をしっかりキープします。
※ SJ-FF50R冷凍ゾーン全体の定格内容積。

大きく透明な氷でひと味違う晩酌に
大小切替/キラット製氷
大きく透明な氷で、溶けにくく飲み物が薄まりにくいです。容器に合わせて氷のサイズを選べます。

おいそぎ冷凍
おいしさを逃さないよう、すばやく冷凍します。
● ステンレストレーは付いていません。
※ 冷凍保存1週間後、室温解凍した場合のシャープ試験比較。食材の種類・状態・解凍方法などにより効果は異なります。

新鮮冷凍
通常冷凍よりさらに低温で保存。また、霜取り運転前やドア開閉後に急冷し、温度上昇を防ぎます。霜つきを抑え、食品の鮮度を守ります。
※ 2023年度機種SJ-GK50K(SJ-FF50Rと同等)にて新鮮冷凍モードと通常冷凍で霜付き状態をシャープ試験にて比較。ドア開閉ありで1か⽉保存。食品の種類や状態などにより効果は異なります。

雪下シャキット野菜室
雪下の環境に近い低温で包み込むように冷やす5面輻射冷却と、うるおいガードで野菜室をまるごと密閉することで、野菜の乾燥を抑えます。
※ 野菜室の食品収納スペースの目安により算出
浮遊菌・付着菌を除菌※1※2※3
毎日使う冷蔵室だから清潔さにもこだわりたい。プラズマクラスターイオン発生ユニット搭載で、きれいな冷気が冷蔵室を循環し、清潔に保ちます。
※1 浮遊菌除菌効果 (1000Lのボックス内での実験結果。実使用空間での実証結果ではありません。)【試験依頼先】(一財)石川県予防医学協会【試験成績書】第14000609号【試験方法】1000Lのボックス内にプラズマクラスターイオンを放出し、その後、浮遊菌をエアーサンプラーを用いて採取し、生菌数を測定(プラズマクラスターイオン濃度:ダクト内200,000個/cm3)【試験対象】浮遊した1種類の菌【対象場所】冷蔵室内【試験結果】約73分で除菌率99%以上。
※2 付着菌除菌効果(100Lのボックス内での実験結果。実使用空間での実証結果ではありません。)【試験依頼先】(一財)石川県予防医学協会【試験成績書】第H1600196K号【試験法】100Lのボックス内に菌を塗布した寒天培地を配置し、プラズマクラスターイオン放出6日後の生菌数を測定(プラズマクラスターイオン濃度:50,000個/cm³)【対象場所】冷蔵室内【試験結果】6日間で除去率99%以上。
※3 使用環境(庫内の食品の量・置き場所など)により、プラズマクラスターイオンの効果が異なることがあります。また、食中毒などの予防を保証するものではありません

チルド棚取り外し清掃
チルド上の棚まで全て取りはずしができるので、今まで掃除ができなかったところまで簡単にお掃除可能に。